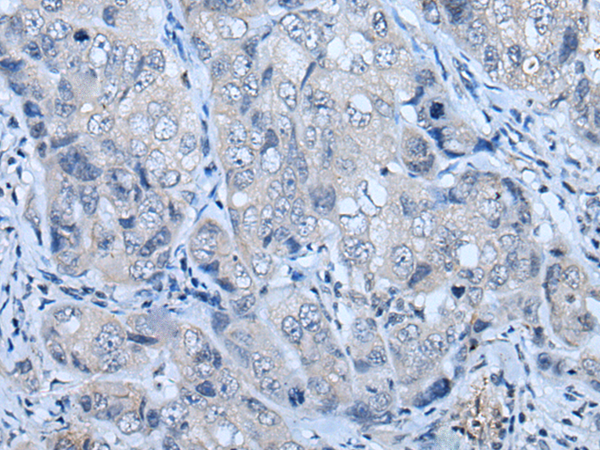

中文名稱: 兔抗POMC多克隆抗體
英文名稱: Anti-POMC rabbit polyclonal antibody
別 名: LPH; MSH; NPP; POC; ACTH; CLIP
相關(guān)類別: 一抗
儲 存: 冷凍(-20℃)
宿 主: Rabbit
抗 原: POMC
反應(yīng)種屬: Human, Mouse
標(biāo) 記 物: Unconjugate
克隆類型: rabbit polyclonal
技術(shù)規(guī)格
|
Background: |
This gene encodes a polypeptide hormone precursor that undergoes extensive, tissue-specific, post-translational processing via cleavage by subtilisin-like enzymes known as prohormone convertases. There are eight potential cleavage sites within the polypeptide precursor and, depending on tissue type and the available convertases, processing may yield as many as ten biologically active peptides involved in diverse cellular functions. The encoded protein is synthesized mainly in corticotroph cells of the anterior pituitary where four cleavage sites are used; adrenocorticotrophin, essential for normal steroidogenesis and the maintenance of normal adrenal weight, and lipotropin beta are the major end products. In other tissues, including the hypothalamus, placenta, and epithelium, all cleavage sites may be used, giving rise to peptides with roles in pain and energy homeostasis, melanocyte stimulation, and immune modulation. These include several distinct melanotropins, lipotropins, and endorphins that are contained within the adrenocorticotrophin and beta-lipotropin peptides. The antimicrobial melanotropin alpha peptide exhibits antibacterial and antifungal activity. Mutations in this gene have been associated with early onset obesity, adrenal insufficiency, and red hair pigmentation. Alternatively spliced transcript variants encoding the same protein have been described. |
|
Applications: |
ELISA, WB, IHC |
|
Name of antibody: |
POMC |
|
Immunogen: |
Synthetic peptide of human POMC |
|
Full name: |
proopiomelanocortin |
|
Synonyms: |
LPH; MSH; NPP; POC; ACTH; CLIP |
|
SwissProt: |
P01189 |
|
IHC positive control: |
Human breast cancer |
|
IHC Recommend dilution: |
20-100 |
|
WB Predicted band size: |
29 kDa |
|
WB Positive control: |
Mouse brain tissue lysate |
|
WB Recommended dilution: |
200-1000 |
購物車
幫助
021-54845833/15800441009
